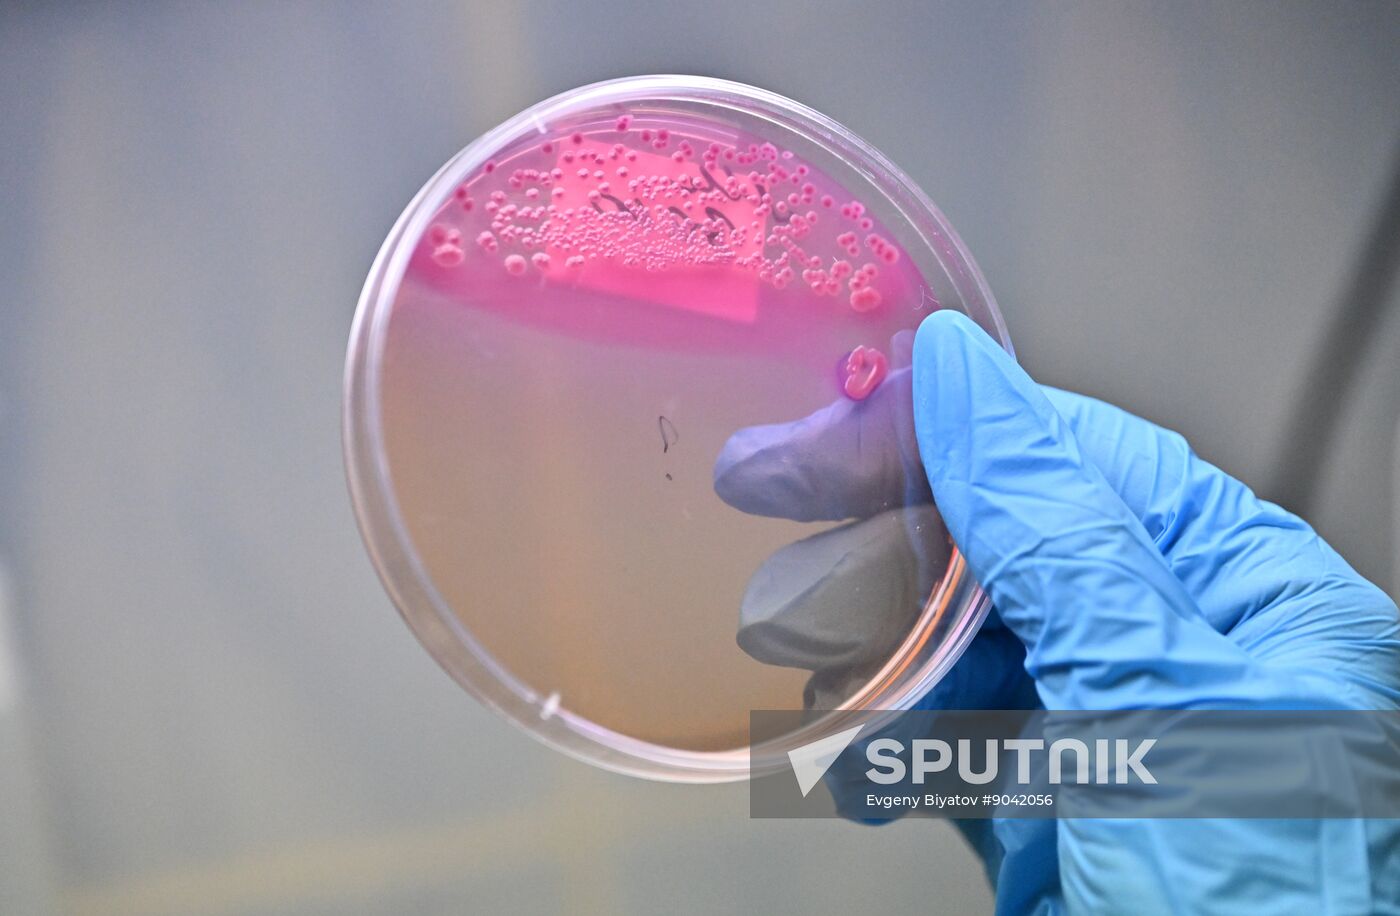
Russia Education Pirogov Medical University

A medical resident holds a Petri dish in a laboratory class during residency training in clinical laboratory diagnostics at the Pirogov Russian National Research Medical University, in Moscow, Russia.
- Author: Evgeny Biyatov
- Credit: Sputnik
- Source: Sputnik
- Original: Digital
- Media: JPEG, 7269x4754px, 17.3Mb
- Job-ID: 8ac41386eb8727c0